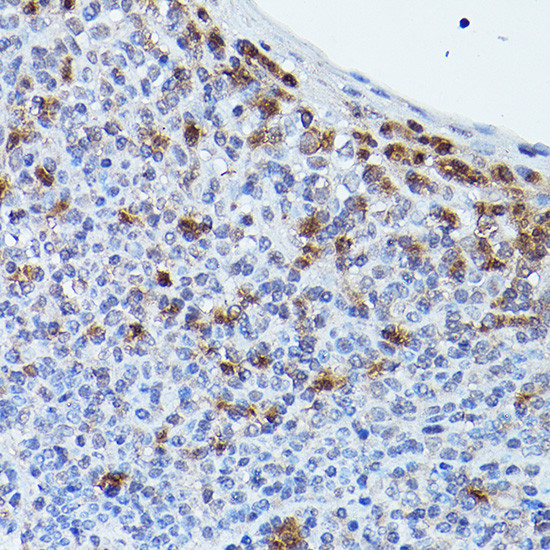
GPR109 Antibody in Immunohistochemistry (Paraffin) (IHC (P))

Search
Invitrogen
GPR109 Polyclonal Antibody
{{$productOrderCtrl.translations['antibody.pdp.commerceCard.promotion.promotions']}}
{{$productOrderCtrl.translations['antibody.pdp.commerceCard.promotion.viewpromo']}}
{{$productOrderCtrl.translations['antibody.pdp.commerceCard.promotion.promocode']}}: {{promo.promoCode}} {{promo.promoTitle}} {{promo.promoDescription}}. {{$productOrderCtrl.translations['antibody.pdp.commerceCard.promotion.learnmore']}}
图: 1 / 3
GPR109 Antibody (PA5-90579) in IHC (P)



Please note: We are reviewing Western blot images included in the antibody testing data in our catalog, including those provided by third parties. Unless expressly labeled or annotated as “raw-unedited”, Western blot images included in the antibody testing data in our catalog may have been edited, optimized or otherwise adjusted for presentation.
产品信息
PA5-90579
种属反应
已发表种属
宿主/亚型
分类
类型
抗原
偶联物
形式
浓度
规格
纯化类型
保存液
内含物
保存条件
运输条件
RRID
产品详细信息
Positive Samples: HepG2, Rat heart
靶标信息
GPR109A (also known as HCA2, HM74a, and NIACR1) is a 42kDa G-protein coupled receptor that belongs to a family of three hydroxyl-carboxylic acid receptors, which also include GPR109B and GPR81. GPR109A has two known ligands: niacin and butyrate (or its derivative 3-hydroxybutyrate). The endogenous ligands for GPR109B and GPR81 are 3-hydroxyl-octanoic acid and 2-hydroxy-propanoate (lactate), respectively. GPR109A is expressed on adipocytes, neutrophils, Langerhans cells, keratinocytes, intestinal epithelial cells, and intestinal colonic macrophages. Niacin, also known as nicotinic acid or vitamin B3, is known to improve cholesterol metabolism (LDL/HDL ratio) and reduce inflammation. It has been demonstrated that this effect is mediated through GPR109A. Notably, GPR109A also has an essential role in suppressing inflammation and cancer in the colon. Both GPR109A ligands are produced by colonic commensal bacteria. In mice, GPR109A expression on intestinal epithelial cells and DCs/macrophages contributes to the suppression of colitis and colon cancer. In humans, GPR109A is silenced in colon carcinoma cells by DNA methylation, which increases inflammation in the intestinal tract.
仅用于科研。不用于诊断过程。未经明确授权不得转售。
生物信息学
蛋白别名: G protein-coupled receptor 109A; G protein-coupled receptor 109B; G protein-coupled receptor HM74a; G-protein coupled receptor 109; G-protein coupled receptor 109A; G-protein coupled receptor HM74; G-protein coupled receptor HM74A; hydroxy-carboxylic acid receptor 2; Hydroxycarboxylic acid receptor 2; interferon-gamma inducible gene, Puma-g; Niacin receptor 1; Nicotinic acid receptor; PUMA-G. GPR109; putative seven transmembrane spanning receptor; unnamed protein product
基因别名: GPR109A; Gpr109b; HCA2; HCAR2; HM74; HM74A; HM74b; mHM74b; NIACR1; PUMA-G; PUMAG
Entrez Gene ID: (Human) 338442, (Mouse) 80885